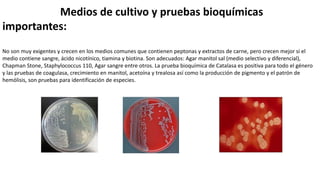
Medios de cultivo y pruebas bioquímicas
importantes:
No son muy exigentes y crecen en los medios comunes que contienen peptonas y extractos de carne, pero crecen mejor si el
medio contiene sangre, ácido nicotínico, tiamina y biotina. Son adecuados: Agar manitol sal (medio selectivo y diferencial),
Chapman Stone, Staphylococcus 110, Agar sangre entre otros. La prueba bioquímica de Catalasa es positiva para todo el género
y las pruebas de coagulasa, crecimiento en manitol, acetoína y trealosa así como la producción de pigmento y el patrón de
hemólisis, son pruebas para identificación de especies.
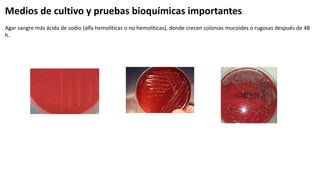
Medios de cultivo y pruebas bioquímicas importantes:
Agar sangre más ácida de sodio (alfa hemolíticas o no hemolíticas), donde crecen colonias mucoides o rugosas después de 48
h.
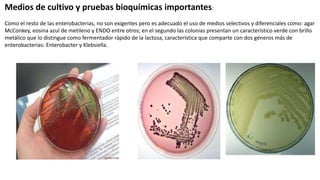
Medios de cultivo y pruebas bioquímicas importantes:
Como el resto de las enterobacterias, no son exigentes pero es adecuado el uso de medios selectivos y diferenciales como: agar
McConkey, eosina azul de metileno y ENDO entre otros; en el segundo las colonias presentan un característico verde con brillo
metálico que lo distingue como fermentador rápido de la lactosa, característica que comparte con dos géneros más de
enterobacterias: Enterobacter y Klebsiella.
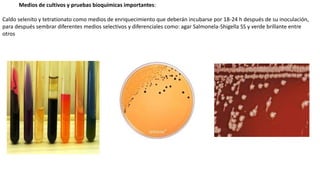
Medios de cultivos y pruebas bioquímicas importantes:
Caldo selenito y tetrationato como medios de enriquecimiento que deberán incubarse por 18-24 h después de su inoculación,
para después sembrar diferentes medios selectivos y diferenciales como: agar Salmonela-Shigella SS y verde brillante entre
otros
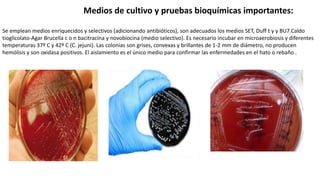
Medios de cultivo y pruebas bioquímicas importantes:
Se emplean medios enriquecidos y selectivos (adicionando antibióticos), son adecuados los medios SET, Duff t y y BU7.Caldo
tioglicolato-Agar Brucella c o n bacitracina y novobiocina (medio selectivo). Es necesario incubar en microaerobiosis y diferentes
temperaturas 37º C y 42º C (C. jejuni). Las colonias son grises, convexas y brillantes de 1-2 mm de diámetro, no producen
hemólisis y son oxidasa positivos. El aislamiento es el único medio para confirmar las enfermedades en el hato o rebaño .
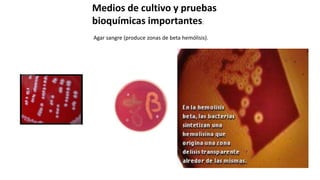
Medios de cultivo y pruebas
bioquímicas importantes:
Agar sangre (produce zonas de beta hemólisis).
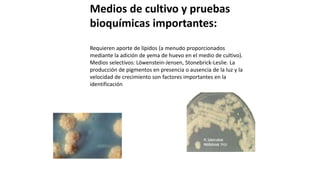
Medios de cultivo y pruebas
bioquímicas importantes:
Requieren aporte de lípidos (a menudo proporcionados
mediante la adición de yema de huevo en el medio de cultivo).
Medios selectivos: Löwenstein-Jensen, Stonebrick-Leslie. La
producción de pigmentos en presencia o ausencia de la luz y la
velocidad de crecimiento son factores importantes en la
identificación
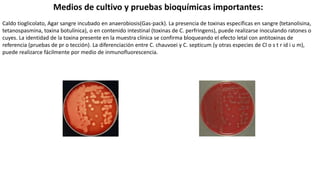
Medios de cultivo y pruebas bioquímicas importantes:
Caldo tioglicolato, Agar sangre incubado en anaerobiosis(Gas-pack). La presencia de toxinas específicas en sangre (tetanolisina,
tetanospasmina, toxina botulínica), o en contenido intestinal (toxinas de C. perfringens), puede realizarse inoculando ratones o
cuyes. La identidad de la toxina presente en la muestra clínica se confirma bloqueando el efecto letal con antitoxinas de
referencia (pruebas de pr o tección). La diferenciación entre C. chauvoei y C. septicum (y otras especies de Cl o s t r id i u m),
puede realizarce fácilmente por medio de inmunofluorescencia.
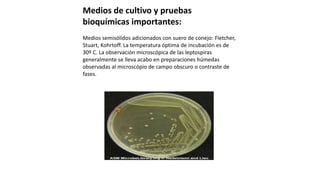
Medios de cultivo y pruebas
bioquímicas importantes:
Medios semisólidos adicionados con suero de conejo: Fletcher,
Stuart, Kohrtoff. La temperatura óptima de incubación es de
30º C. La observación microscópica de las leptospiras
generalmente se lleva acabo en preparaciones húmedas
observadas al microscópio de campo obscuro o contraste de
fases.
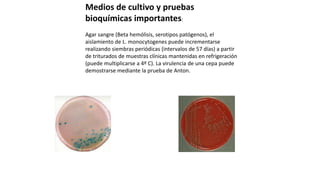
Medios de cultivo y pruebas
bioquímicas importantes:
Agar sangre (Beta hemólisis, serotipos patógenos), el
aislamiento de L. monocytogenes puede incrementarse
realizando siembras periódicas (intervalos de 57 días) a partir
de triturados de muestras clínicas mantenidas en refrigeración
(puede multiplicarse a 4º C). La virulencia de una cepa puede
demostrarse mediante la prueba de Anton.
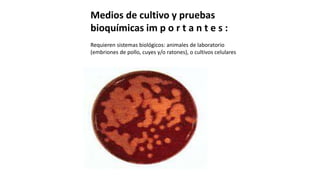
Medios de cultivo y pruebas
bioquímicas im p o r t a n t e s :
Requieren sistemas biológicos: animales de laboratorio
(embriones de pollo, cuyes y/o ratones), o cultivos celulares

Este documento describe varios géneros bacterianos de importancia veterinaria, incluyendo sus características, especies relevantes, factores de virulencia y enfermedades asociadas. Describe Staphylococcus, Streptococcus, Corynebacterium, Erysipelothrix, Escherichia, Salmonella y Campylobacter, proporcionando detalles sobre sus propiedades y rol en patologías animales.